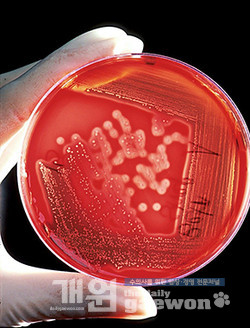

Midwestern Pet Foods Inc.가 70마리 이상의 반려견 사망과 관련이 있을 수 있는 제품을 리콜한 지 몇 개월만에 살모넬라에 오염됐을 수 있는 일부 개와 고양이 사료를 자발적으로 리콜하고 있다.
Midwestern Pet Foods Inc.은 최근 미국 FDA(식품의약국) 사이트에 게시한 리콜 공지를 통해 “개와 고양이 사료 브랜드 10개의 특정 로트 및 만료일에 대해 리콜 조치한다”고 밝혔다.
아울러 리콜된 제품을 반려동물이나 다른 동물에게 먹이지 말 것을 권고하고, 제품 전량을 회수 조치했다.
Midwestern Pet Foods Inc. 측은 “리콜은 완제품에 박테리아가 포함되어 있을 수 있음을 밝힌 일상적인 샘플링 결과 조치다. 다른 모든 제품은 이번 리콜의 영향을 받지 않는다”며 “지금까지 사람 또는 반려동물 질환에 대한 보고는 없었다”고 밝혔다.
FDA와 당사 홈페이지에는 리콜 해당 브랜드 리스트를 게시했다.
문제가 된 제품은 일리노이주 몬 머스 생산시설에서 생산된 CanineX, Earthborn Holistic, Venture, Unrefined, Sportmix Wholesomes, Pro Pac, Pro Pac Ultimates, Sportstrail, Sportmix, Meridian 등 10개 브랜드이다.
Midwestern Pet Foods Inc.는 “우리 제품은 100년 동안 안전하고 영양가 있는 제품을 보장하기 위해 노력해온 4세대 가족회사”라며 “어린이나 반려동물, 야생동물이 접근할 수 없도록 음식을 폐기할 것과 리콜 식품과 해당 식품에 접촉한 모든 식기를 세척하고, 항상 손을 씻고 살균할 것”을 권유했다.
지난해 12월 Midwestern Pet Foods Inc. 사료는 여러 차례 반려견 사망과 관련이 있어 곰팡이의 부산물인 안전하지 않은 수준의 아플라톡신을 포함할 수 있다는 보고를 받은 후 일부 Sportmix 반려동물 사료를 회수했다.
이어 올해 1월 더 많은 브랜드와 제품으로 리콜이 확대 되었고, FDA는 조사 중이라고 밝혔다.
해당 제품, 로트 번호, UPC 코드, 만료 날짜 등 전체 목록은 사이트(www.midwesternpetfoods.com)에서 확인 가능하다.
by Kelly Tyko USA TODAY 2021. 3. 30.


